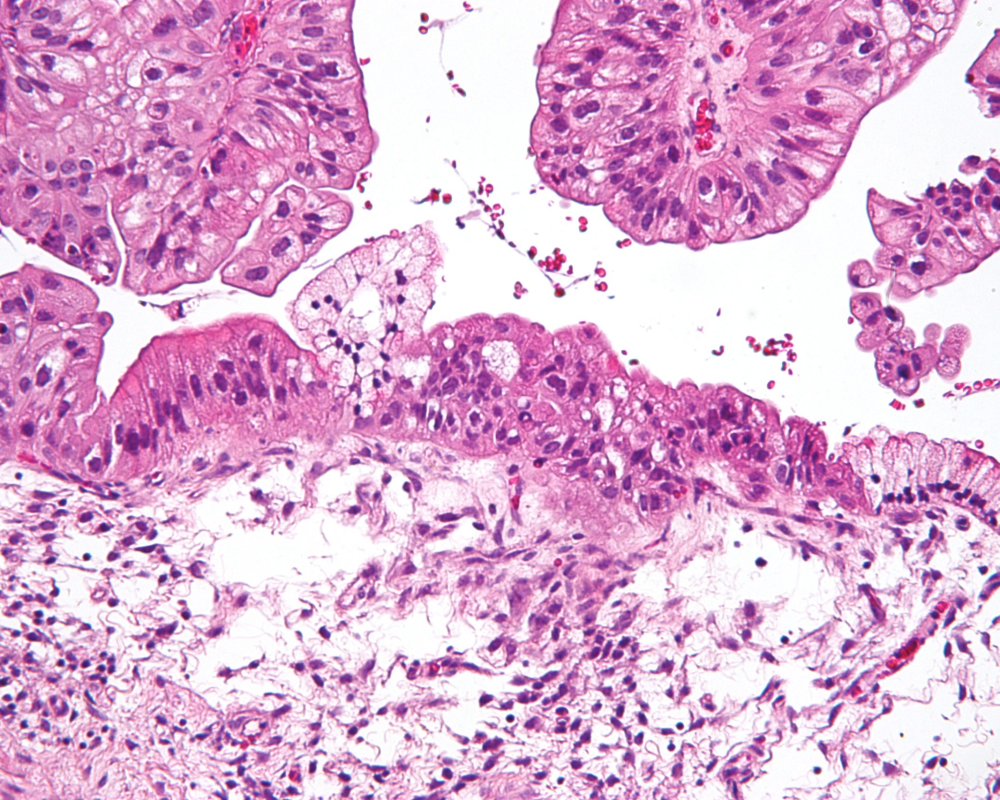
News Main Image

بيت لحم/PNN- قالت صحيفة "لوفيغارو" الفرنسية، إن حالة واحدة من كل عشر حالات سرطان لدى النساء ترتبط بمجال أمراض النساء، وفقًا لبيانات عام 2023.
وأوضحت الصحيفة الفرنسية، في تقرير لها، أنه في كل عام، يتم تشخيص إصابة 17000 امرأة بنوع من أنواع سرطانات النساء.
وأوضحت الصحيفة أن سرطان الرحم يأتي في المقدمة بواقع 8400 حالة، وفقًا لأحدث البيانات الصادرة عن هيئة الصحة العامة الفرنسية.
وتعد هذه الإحصاتية بالفعل أقل شيوعاً بكثير من سرطان الثدي الذي يسجل ما يزيد قليلاً عن 61 ألف حالة هذا العام)، وهذه السرطانات آخذة في التناقص بشكل عام، باستثناء سرطان عنق الرحم الذي يميل إلى الاستقرار بعد عدة عقود من الانخفاض.
ويعد سرطان بطانة الرحم السبب الرئيسي الرابع للسرطان لدى النساء في فرنسا، حيث يؤثر بشكل رئيسي على النساء بعد انقطاع الطمث، حيث يبلغ متوسط العمر عند التشخيص 68 عامًا، وتتمثل أعراضه بوجود نزيف في الأعضاء التناسلية.
وحذر البروفيسور فنسنت لافوي، رئيس قسم جراحة أمراض النساء في مستشفى جامعة رين من سرطان بطانة الرحم الذي يتم تعريفه، على أنه تكاثر الخلايا بشكل غير منضبط، وهي عبارة عن كتلة هشة مكونة من خلايا وأوعية دموية يمكن أن تتدفق وبالتالي يمكن أن تبدأ بالنزيف بسهولة.
ولفت الى أن عامل الخطر الكبير هو زيادة الوزن، لذلك يجب على المرأة التي وصلت إلى سن اليأس وتعاني من زيادة الوزن أن تكون حذرة بشكل خاص بشأن النزيف المهبلي.
وأوضح ان النزيف ليس حتميا في كل الحالات ولكن من النادر جدًا عدم وجود نزيف على الإطلاق في حالات سرطان عنق الرحم أو بطانة الرحم.
وأشار لافوي، إن سرطان عنق الرحم يصيب النساء الأصغر سنًا بقليل، أي حوالي 45 عامًا في المتوسط، موضحاً أن 99٪ مرتبط بالتلوث بفيروس الورم الحليمي وأن العرض الرئيسي الذي يجب أن ينبهك هو وجود نزيف في الأعضاء التناسلية.
سرطان المبيض "الصامت"
ومن بين جميع أنواع سرطانات الأعضاء التناسلية، ويكون تشخيصه هو الأسوأ، حيث يمكن اكتشافه بالصدفة أثناء فحص أمراض النساء أو التصوير، ولكن غالبًا ما يتم تشخيصه متأخرًا، عندما تكون الخلايا السرطانية قد هاجرت بالفعل إلى أعضاء أخرى، ولاسيما أن المبيضين حران في تجويف البطن، فيمكن للخلايا السرطانية أن تنتشر بسهولة.
وقال البروفيسور لافوي: " إنه سرطان يتطور بسرعة كبيرة، نحن نتحدث عن القاتل الصامت لأن أعراضه لا تظهر إلا عندما يكون في مرحلة متقدمة بالفعل".
وأردف: "في هذه الحالة، يمكن أن يظهر المرض من خلال علامات مختلفة، مثل الشعور بعدم الراحة والألم في البطن، أو زيادة تدريجية في حجم البطن، أو إفرازات مهبلية غير طبيعية أو حتى التعب"، مبينا ان جميع استراتيجيات الفحص التي تم اختبارها حتى الآن باءت بالفشل.
وأوضح ان سرطان المبيضين يصيب بشكل رئيسي النساء بعد انقطاع الطمث، بالإضافة إلى العمر، فإن عدم الإنجاب، والحيض المبكر وانقطاع الطمث المتأخر كلها عوامل من المحتمل أن تزيد من خطر الإصابة بسرطان المبيض.
وتشير التقديرات إلى أن 15 إلى 20% من حالات سرطان المبيض تكون بسبب خلل وراثي، نظرًا لأنه لا يظهر إلا عندما يكون الوضع خطيرًا بالفعل، فإن هذا السرطان هائل بشكل خاص، حيث يموت حوالي نصف المرضى في غضون خمس سنوات من التشخيص، وفقًا لبيانات عام 2018.
وأشارت الصحيفة إلى السرطانات الأكثر ندرة، وهي الفرج والمهبل تؤثر بشكل رئيسي على النساء الأكبر سنا.
وأضاف انه يتم تشخيص ما يزيد قليلاً عن 900 حالة من حالات سرطان الفرج كل عام، بشكل عام لدى الأشخاص الذين تزيد أعمارهم عن 70 عامًا "،مبينا ان التشخيص سهل لأنه سرطان يظهر على شكل كرة على السطح.
ومع ذلك، ما زلنا نكتشفه في مراحل متقدمة لأنه غالباً ما يتعلق بالنساء المعالات، في دور رعاية المسنين على سبيل المثال.
وشددت الصحيفة على أن ما بعد انقطاع الطمث تعد فترة يجب الانتباه لها في حياة المرأة. وكثيرًا ما يقوم المرضى الأصغر سنًا بزيارة طبيب أمراض النساء أو القابلة، سواء لمنع الحمل أو الحمل أو مرحلة ما قبل انقطاع الطمث، ولكننا نرى أنه بعد انقطاع الطمث، تتوقف بعض النساء عن الاستشارة.
ومع ذلك، لا ينبغي إغفال أي أعراض، خاصة عندما يتعلق الأمر بالإفرازات غير الطبيعية أو النزيف، إن مجرد وصولنا إلى سن اليأس لا يعني أننا يجب أن ننسى صحتنا التناسلية.
المصدر: صحيفة "لو فيغارو" الفرنسية